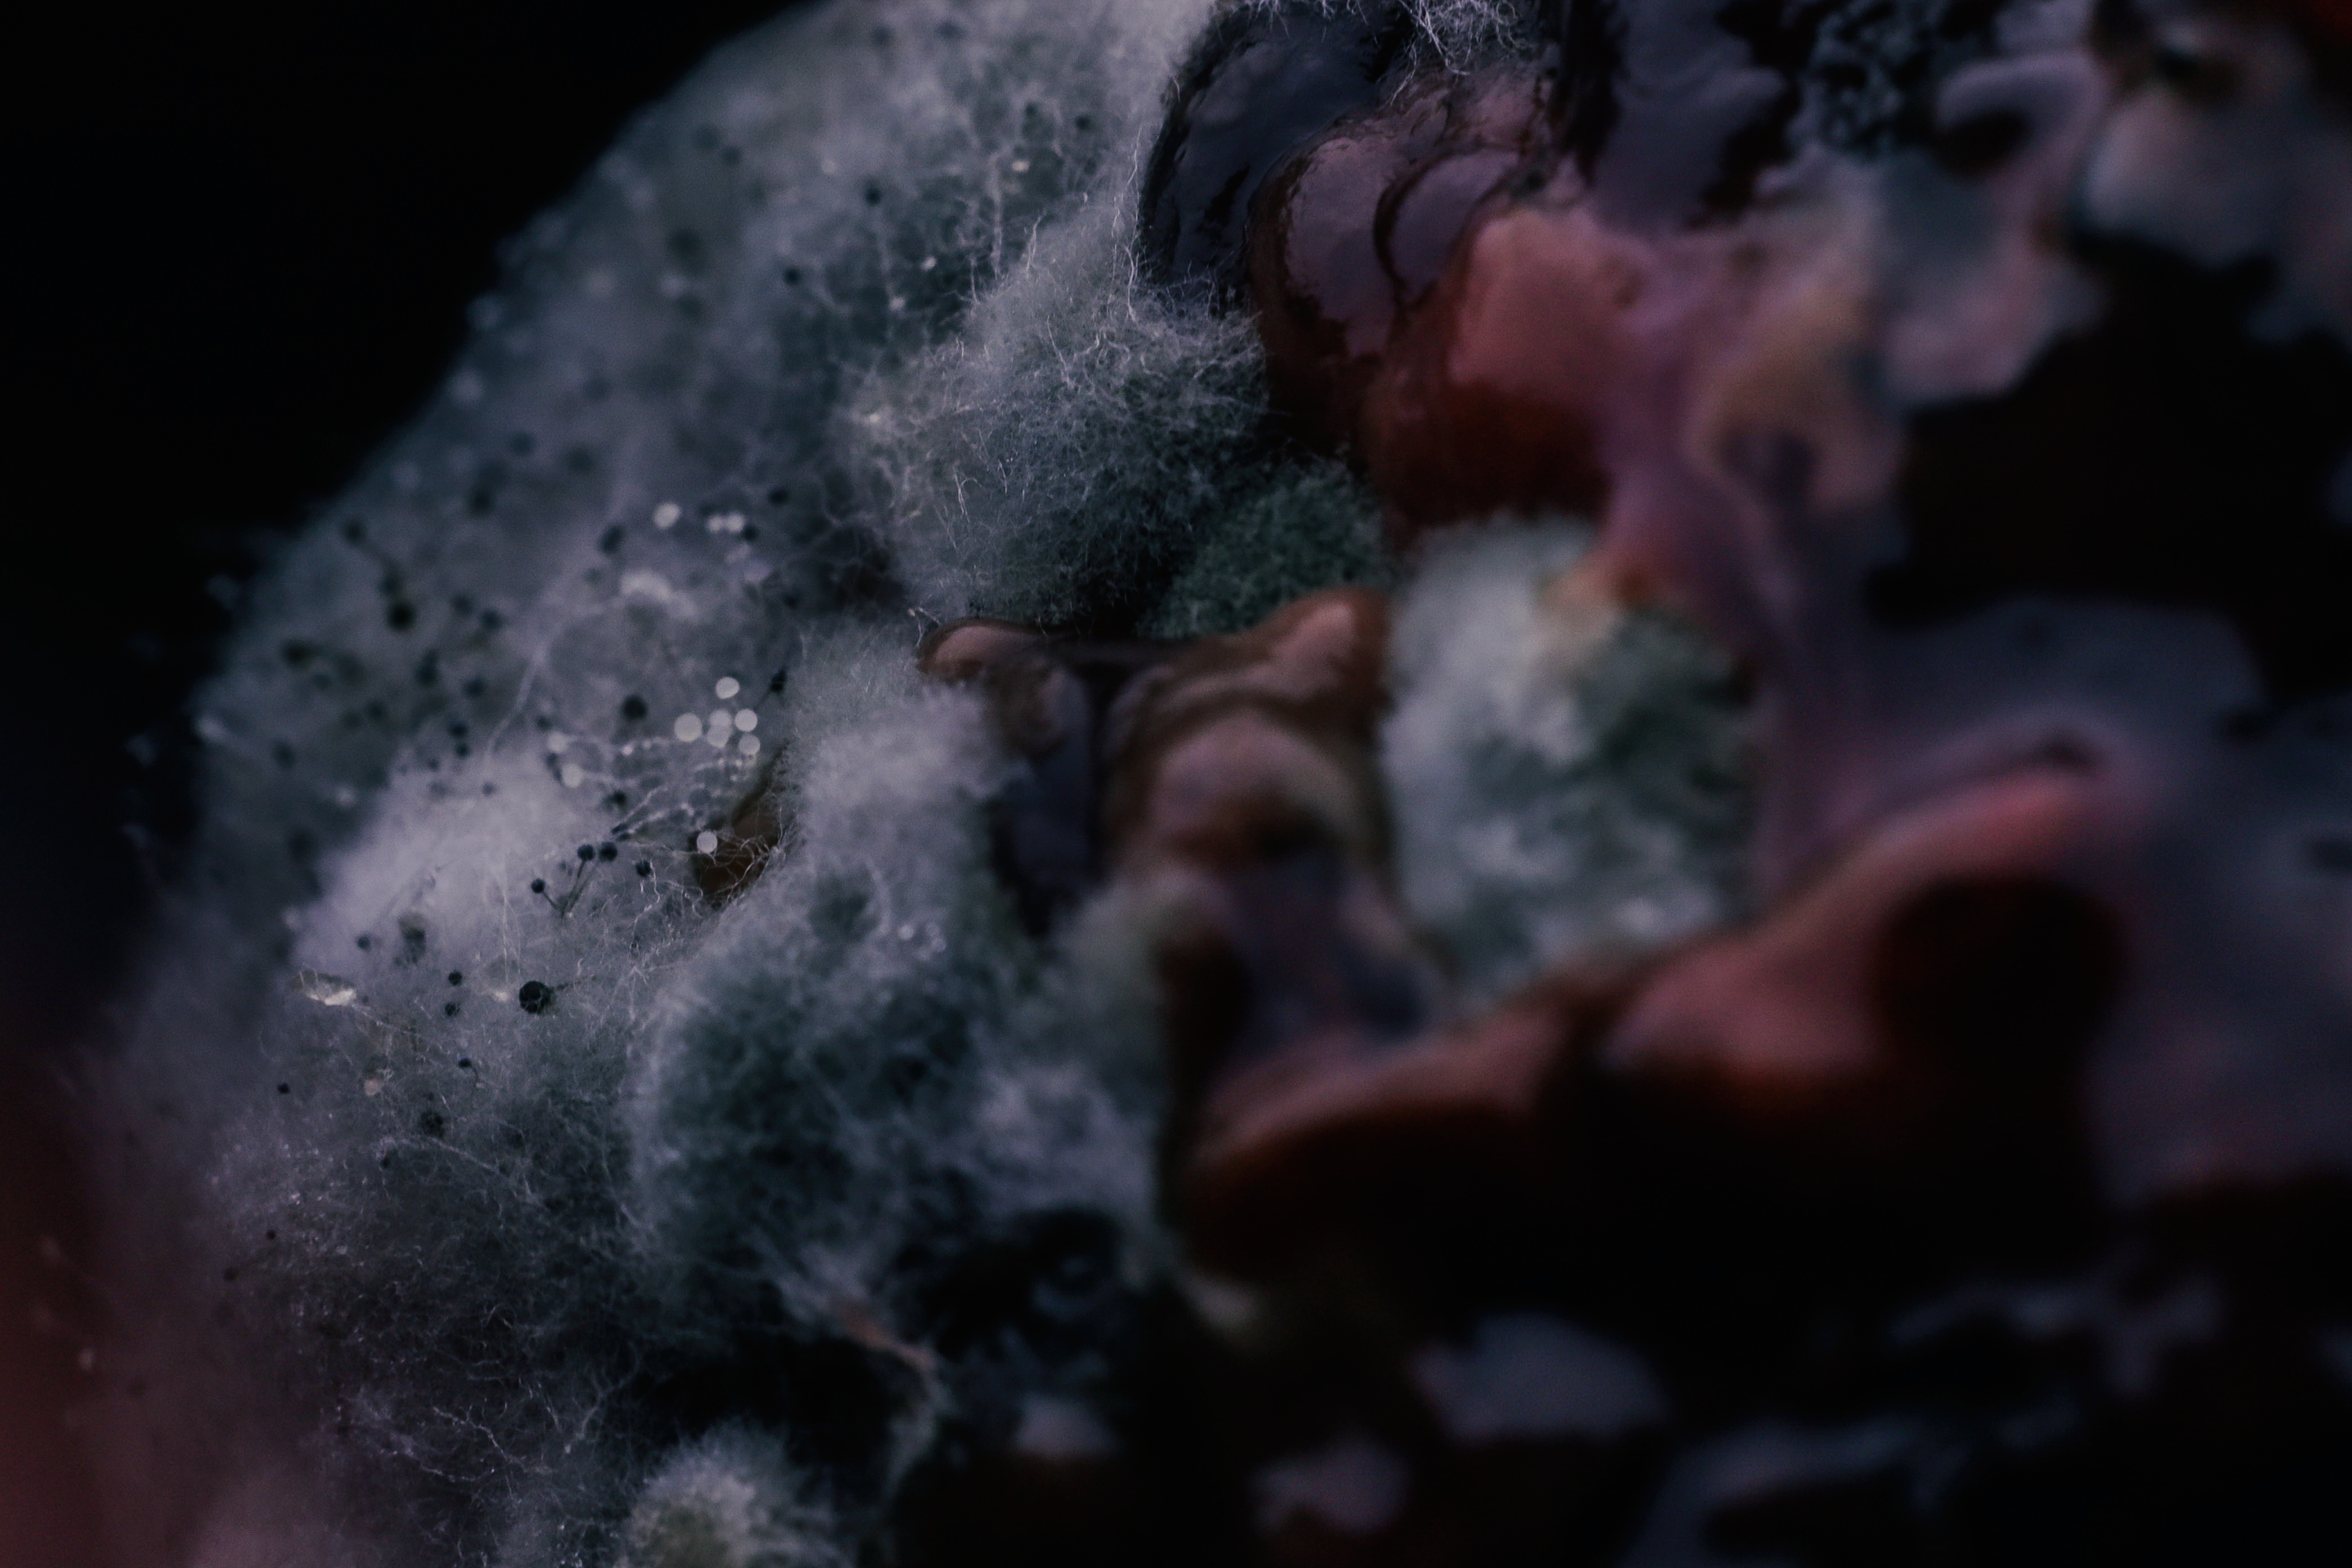

Total ETH Value
0.0000000000 
Global Rank
#9,999,999
User Percentile
%
Total Like
0
Profile Information
As an multimedia artist I try not to limit myself and to be able to find different forms of expression.
I also generate new media art compositions as well as getting into macro worlds.
This site has been specially prepared for the "LucasGarcias" user, and "Lucas Garcías " can make any changes to this site if he wishes. In order to access the site content, you need to log in with the metamask wallet.
When you log in, the site will automatically recognize you and you will be able to change your own page.
Anyone who donates to our wallet number at the bottom of the page will automatically gain VIP user status, regardless of small or large size, and will be able to benefit from all services on the site free of charge for life. Thank you for supporting us in this matter.
Rare 3d Metaverse Project